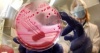
В Приморье в импортной пищевой продукции обнаружены опасные бактерии

Новости отрасли

|
ВАС отклонил заявление "Мираторга" по спору с проектировщиком склада 05.06.2013 |

|
15 июня состоится торжественная церемония открытия «Улан-Удэнского мясоперерабатывающего комплекса» 05.06.2013 |

|
На «АмурЭкспоФоруме» презентуют «юбилейную» колбасу 05.06.2013 |

|
В Курской области снимают карантин по сибирской язве 05.06.2013 |
Производство молока, яиц и мяса дешевле и экологически безопаснее - цель проекта «Экотерритория АГРО-2013»
05.06.2013

|
Беларусь заинтересована в создании СП по переработке мяса и молока с Краснодарским краем 05.06.2013 |

|
Испания провела тщательную проверку производителей продуктов питания и надеется на возобновление поставок в Россию - министр 05.06.2013 |

|
В Калмыкии строят агрокомплекс для выхода на мировые рынки 05.06.2013 |
|
В Приморье в импортной пищевой продукции обнаружены опасные бактерии 05.06.2013 |
Ставропольский край: В надежде на инвестиции
05.06.2013


